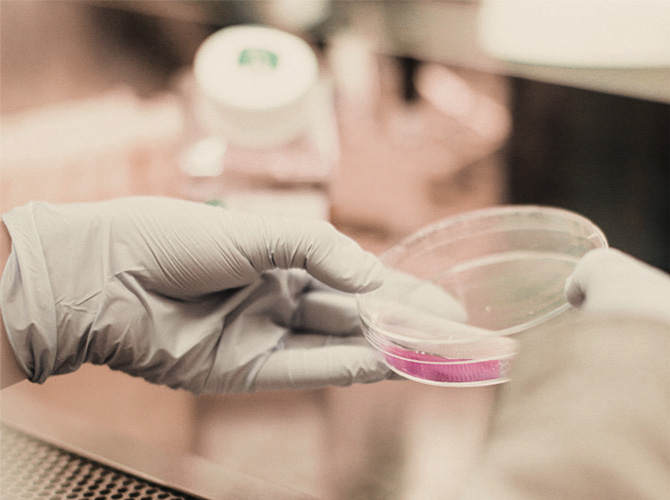

Lääketieteen, lääketeollisuuden ja lääkinnällisten laitteiden teksteille tunnusomaista on vaatimustenmukaisuus, lainsäädäntö ja vakiintuneet käytännöt. Reilun kymmenen vuoden kokemus lääketieteen teksteistä takaa, että tiedän, millaisia lakisääteisiä vaatimuksia mihinkin tekstityyppiin kohdistuu. Lääketieteen alalla käännän ja oikoluen mm. lääkevalmisteiden valmisteyhteenvetoja ja pakkausselosteita, kliinisten lääketutkimusten materiaaleja, potilaille ja terveydenhuollon ammattilaisille suunnattuja aineistoja ja lääkinnällisten laitteiden ja näihin liittyvien ohjelmistojen erilaisia manuaaleja.
Lääketiede
Yritysviestintä ja markkinointi
Yritysviestinnän ja markkinoinnin kääntäjän kynään tarvitaan oikeassa suhteessa luovuutta ja asiasisällön ja asiakkaan termien täsmällistä hallintaa. Toki tämä tekstityyppi pyrkii herättämään huomion ja rakentamaan mielikuvia, mutta käännösprojekteissa kyseessä ei ole kepeä copy, vaan julkaisu, joka usein markkinointityylistään huolimatta vilisee asiakkaan teknisiä termejä. Niiden oikeellisuus käännetyssä tekstissä on aivan yhtä tärkeää kuin toivotulla tavalla soljuvan tekstin ja oikean sävyn ja tunnelman saavuttaminen. Käännän ja oikoluen paljon yritysten sisäisen ja ulkoisen viestinnän materiaaleja, kuten erilaisia esitteitä, koulutusmateriaaleja ja yritysten somekanavissaan julkaisemaa sisältöä.
Kuluttajaviestintä ja käyttöohjeet
Kohdekielinen käännös käyttöohjeesta on hyvin monen kuluttajatuotteen markkinoille tulon edellytys. Vaikka osa yrityksistä luottaa tässä edelleen konekäännöksen voimaan, valtaosa ymmärtää, että käyttöohjeen asianmukainen ja laadukas käännös tuo yritykselle ja sen tuotteille uskottavuutta. Erilaisten kuluttajille suunnattujen suurten ja pienten tuotteiden ja palveluiden käyttöohjeet, esitteet ja markkinointimateriaalit ovat käännösammattilaisten yksi suurimmista ja varmimmista työllistäjistä.
Tekniset tekstit ja tuotedokumentaatio
Tekniset tekstit ja tuotedokumentaatio kattaa suuren joukon kansainvälisesti toimivien teknisen alan yritysten erilaista tekstisisältöä. Teknisissä teksteissä keskeistä on termien ehdoton oikeellisuus ja tekstin selkeys, joka ei jätä varaa tulkinnoille. Teknisellä alalla käännän asiakkailleni esimerkiksi erilaisia ammattilaisille suunnattuja asennus- ja huolto-ohjeita, teknisiä kuvauksia ja teknisen henkilöstön koulutusmateriaaleja ja verkkokursseja.